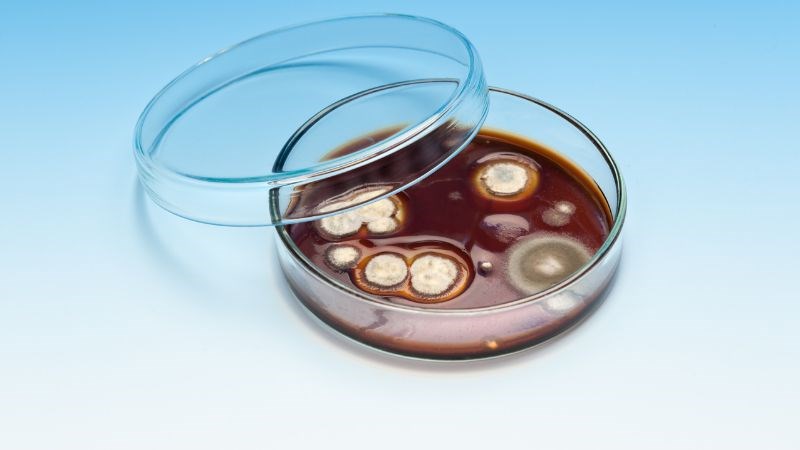

Nấm mắt là tình trạng hiếm gặp nhưng có thể gây ra nhiều ảnh hưởng nghiêm trọng cho sức khỏe. Nếu không được điều trị sớm, bệnh nấm mắt có thể gây ra các biến chứng nặng nề tới giác mạc như mất thị giác, loét hoặc thủng giác mạc. Hãy cùng tìm hiểu rõ hơn về bệnh nấm mắt qua bài viết này nhé!
1Nhiễm nấm mắt là bệnh gì?
Nhiễm nấm mắt là bệnh nhiễm trùng do nhiều nguyên nhân khác nhau gây ra bao gồm vi khuẩn, virus, amip và nấm. Ở Việt Nam số người mắc bệnh nấm mắt khá cao. Có thể là do đặc điểm khí hậu nóng ẩm tạo điều kiện thuận lợi cho các loại nấm phát triển.
Nấm mắt có thể xảy ra ở nhiều phần khác nhau như:
- Viêm giác mạc là tình trạng viêm nhiễm ở giác mạc, đây là tình trạng phổ biến nhất của bệnh nấm mắt
- Viêm nội nhãn là tình trạng viêm nhiễm bên trong mắt có thể là thủy dịch hoặc thủy tinh thể [1]

Nấm mắt là bệnh nhiễm trùng do nhiễm nấm
2Tác nhân gây nấm mắt
Có rất nhiều loại nấm khác nhau gây bệnh nấm mắt. Các loại nấm gây bệnh phổ biến bao gồm:
- Fusarium – một loại nấm sống trong môi trường, đặc biệt là trong đất và trên thực vật. Đây là loại nấm gây tổn thương nặng nề cho mắt.
- Aspergillus – một loại nấm phổ biến sống ở môi trường trong nhà và ngoài trời
- Candida – một loại nấm men thường sống trên da người và trên lớp màng bảo vệ bên trong cơ thể gọi là màng nhầy [2]
Sau khi vào mắt, các loại nấm này sẽ sinh ra độc tố gây hoạt hóa enzyme phân giải protein trong mắt, làm hủy hoại màng mắt.
3Yếu tố nguy cơ
Bệnh có thể xảy ra ở mọi lứa tuổi, bất cứ ai cũng có thể bị nhiễm nấm mắt. Có rất nhiều yếu tố làm tăng nguy cơ mắc bệnh nhiễm nấm mắt bao gồm:
- Chấn thương mắt.
- Phẫu thuật mắt như phẫu thuật ghép giác mạc, phẫu thuật đục thủy tinh thể.
- Các bệnh mắt mãn tính.
- Đeo kính áp tròng.
- Tiếp xúc với các sản phẩm y tế bị ô nhiễm.
- Nhiễm nấm máu. [1]

Đeo kính áp tròng không đúng cách cũng là nguyên nhân gây nhiễm nấm mắt
4Triệu chứng nấm mắt
Các triệu chứng của bệnh nấm mắt có thể xuất hiện bất cứ lúc nào từ vài ngày đến vài tuần sau khi tiếp xúc với tác nhân gây bệnh. Các triệu chứng nhiễm trùng mắt do nấm mắt bao gồm:
- Đau mắt
- Đỏ mắt
- Suy giảm thị lực (mờ mắt)
- Nhạy cảm với ánh sáng
- Chảy nước mắt nhiều
- Mắt bị tổn thương (bị rách quá mức) [2]

Đỏ mắt là một trong các triệu chứng của bệnh nhiễm nấm mắt
5Biến chứng nguy hiểm
Bệnh nấm mắt là một bệnh hiếm gặp, nhưng nếu không được phát hiện sớm và điều trị đúng cách sẽ ảnh hưởng nghiêm trọng đến thị lực như:
- Viêm loét giác mạc
- Viêm nội nhãn
- Nhiễm trùng mắt
Nếu không được điều trị nấm mắt kịp thời, lâu dần sẽ dẫn đến giảm thị lực vĩnh viễn và thậm chí là mù lòa.

Nhiễm nấm mắt không được điều trị kịp thời và đúng cách sẽ dẫn đến mù lòa
6Cách chẩn đoán
- Soi kính hiển vi: có thể xác định được nấm bằng cách xem mẫu dưới kính hiển vi.
- Nuôi cấy nấm: đa số các loài nấm gây viêm mọc trong 2 – 3 ngày, nhưng cũng có một số loại nấm mất 5 – 7 ngày mới mọc.
- Xét nghiệm PCR: xét nghiệm để xác định gen đặc trưng cho vi nấm của bệnh nhiễm trùng nấm mắt. [2]

Nuôi cấy nấm giúp xác định chủng loại nấm mà người bệnh mắc phải
7Khi nào cần gặp bác sĩ?
Dấu hiệu cần gặp bác sĩ
Khi bạn nghi ngờ có các dấu hiệu của bệnh nấm mắt như mờ mắt, nhạy cảm với ánh sáng, đau mắt, đỏ mắt. Hãy đến gặp bác sĩ ngay để được thăm khám và điều trị kịp thời.
Nơi thăm khám bệnh và điều trị bệnh nấm mắt
Nếu gặp các dấu hiệu như trên, bạn có thể đến ngay các cơ sở y tế gần nhất, các bệnh viện chuyên khoa Nhãn khoa. Hoặc bất kỳ bệnh viện đa khoa nào tại địa phương để được thăm khám kịp thời.
Ngoài ra, có thể tham khảo một số bệnh viện lớn, uy tín dưới đây để được chẩn đoán và tư vấn điều trị phù hợp, tránh các biến chứng đáng tiếc xảy ra:
- Tại TP. HCM: Bệnh viện Mắt TP.HCM, Bệnh viện Gia An 115, Bệnh viện Chợ Rẫy, Bệnh viện Đại học Y dược TP.HCM.
- Tại Hà Nội: Bệnh viện Mắt Trung Ương, Bệnh viện Mắt Hà Nội 2, Bệnh viện Bạch Mai, Bệnh viện Đại học Y Hà Nội.

Nếu nghi ngờ nhiễm nấm mắt hãy đến gặp bác sĩ để được thăm khám kịp thời
8Cách điều trị bệnh nấm mắt
Sau khi thăm khám, bác sĩ sẽ xác định loại nấm đang nhiễm, mức độ nghiêm trọng của bệnh, tình trạng sức khỏe của bệnh nhân,.. Để đưa ra phương pháp và loại thuốc điều trị phù hợp.
- Thuốc mỡ tra mắt: thuốc kháng nấm dạng nhỏ mắt ví dụ Natamycin.
- Thuốc kháng nấm đường uống: điều trị bằng đường uống được khuyên dùng: voriconazole, fluconazole (nếu Candida) hoặc itraconazole (nếu Aspergillus). Các liệu pháp thay thế bao gồm miconazole bôi tại chỗ (1%) và tiêm dưới kết mạc (10 mg) hoặc hỗn dịch itraconazole bôi tại chỗ (1%). Trị liệu thường được tiếp tục trong ít nhất 14 ngày.
- Thuốc kháng nấm đường tiêm: Tiêm amphotericin B hoặc voriconazole trong dịch kính hoặc cắt dịch kính.
- Phẫu thuật: Những bệnh nhân bị nhiễm trùng nấm mắt không thuyên giảm các triệu chứng sau khi sử dụng thuốc chống nấm có thể cần phẫu thuật bao gồm ghép giác mạc, loại bỏ gel thủy tinh thể từ bên trong mắt (cắt bỏ dịch kính), hoặc trong trường hợp nặng hơn phải loại bỏ mắt (lọc nhân).[1]
9Biện pháp phòng ngừa
- Những người làm việc trong môi trường ô nhiễm cần phải đeo kính bảo hộ đầy đủ.
- Rửa tay và mắt thật sạch ngay sau khi bạn tiếp xúc với các tác nhân gây bệnh, khám mắt ngay nếu cần thiết.
- Đeo kính để bảo vệ mắt khi đi ra ngoài đường.
- Không dùng tay dụi mắt, rửa mắt bằng nước sạch hoặc nước muối sinh lý.
- Phải đảm bảo vệ sinh kính áp tròng và chăm sóc mắt đúng quy trình.
- Không tự ý sử dụng thuốc khi thấy xuất hiện các triệu chứng đau, rát, đỏ mắt.[2]

Đeo kính để bảo vệ mắt khi đi ra ngoài đường
Bài viết này đã cung cấp thông tin cho bạn về nguyên nhân, triệu chứng, cách điều trị bệnh nấm mắt. Nếu thấy bài viết này hay và bổ ích, hãy chia sẻ thông tin này đến mọi người xung quanh bạn nhé!
Nguồn tham khảo
Xem thêm